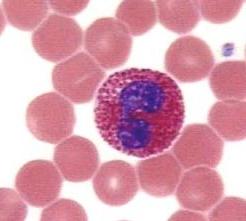

В статье рассмотрим причины повышения уровня эозинофилов в крови у мужчин. Эозинофилы — это разновидность лейкоцитов, играющие важную роль в иммунной системе. Их увеличение может указывать на аллергические реакции, инфекции или другие патологии. Понимание факторов, влияющих на уровень этих клеток, поможет читателям ориентироваться в своем здоровье и своевременно обращаться за медицинской помощью.
Содержание:
Эозинофилы увеличиваются в количестве, когда организм подвергается воздействию паразитов или при возникновении аллергических реакций. Эти клетки формируются в костном мозге в ответ на проникновение в организм чуждых белков. Врач может определить повышенный уровень эозинофилов в крови пациента, анализируя результаты обычного анализа крови.
Повышение уровня эозинофилов в крови у мужчин может быть связано с различными факторами. Врачи отмечают, что одной из основных причин является аллергическая реакция, которая может возникать на продукты, пыльцу или медикаменты. Кроме того, инфекционные заболевания, особенно паразитарные, также могут приводить к увеличению количества этих клеток. В некоторых случаях эозинофилия может быть следствием аутоиммунных заболеваний, таких как системная красная волчанка или болезнь Крона. Врачи подчеркивают важность комплексного обследования для выявления точной причины повышения эозинофилов, так как это может быть признаком серьезных заболеваний. Регулярные медицинские осмотры и анализы крови помогут своевременно обнаружить и устранить возможные проблемы со здоровьем.
https://youtube.com/watch?v=OAYR2dDkVSw
Эозинофилия и её причины
Важно! Уровень эозинофилов, превышающий 7% от общего числа лейкоцитов, считается повышенным. Легкая форма характеризуется показателями до 10%, средняя — от 10% до 15%, а все значения выше 15% относятся к тяжелой форме.
Когда уровень эозинофилов превышает норму, это сигнализирует о наличии патологического процесса в организме.
Эозинофилы в крови
Причины повышения эозинофилов у взрослых могут быть связаны с рядом факторов:
- Аллергические реакции. Это может проявляться в виде симптомов бронхиальной астмы и различных дерматитов.
- Инвазивные заболевания, такие как аскаридоз, описторхоз и лямблиоз.
- Инфекционные болезни и расстройства пищеварительной системы на стадии выздоровления.
- Онкологические заболевания, при которых происходит разрушение тканей. Эозинофилы реагируют на продукты распада, воспринимая их как чуждые белки.
- Заболевания органов дыхания.
- Инфаркт миокарда.
- Повышение уровня эозинофилов может наблюдаться как у взрослых, так и у детей при применении определенных медикаментов. Антибиотики, салицилаты, сульфаниламиды и йодаты могут вызывать аллергические реакции, что приводит к эозинофилии.
- Пищевая аллергия. Она может развиваться при употреблении некоторых сезонных овощей, ягод, грибов, рыбы и морепродуктов.
- Аллергические реакции, возникающие во время беременности или в критические дни.
В современной медицине для диагностики сифилиса применяются различные тесты, среди которых реакция Вассермана. Хотя классический метод в настоящее время не используется, он стал основой для большинства современных схем выявления этого опасного заболевания.
Важно! Употребление цитрусовых перед сдачей крови на стандартный анализ может привести к ложным показателям эозинофилии.
Аллергия является одной из основных причин повышения уровня эозинофилов.
| Категория причин | Примеры заболеваний/состояний | Дополнительные комментарии |
|---|---|---|
| Аллергические реакции | Бронхиальная астма, аллергический ринит, атопический дерматит, пищевая аллергия, лекарственная аллергия | Наиболее частая причина эозинофилии. Может быть сезонной или круглогодичной. |
| Паразитарные инвазии | Аскаридоз, токсокароз, трихинеллез, лямблиоз, шистосомоз, эхинококкоз | Эозинофилы активно участвуют в борьбе с паразитами. Степень эозинофилии зависит от вида паразита и стадии инвазии. |
| Аутоиммунные заболевания | Системная красная волчанка, ревматоидный артрит, васкулиты (например, эозинофильный гранулематоз с полиангиитом) | Эозинофилы могут участвовать в патогенезе аутоиммунных процессов. |
| Опухолевые заболевания | Лимфома Ходжкина, некоторые виды лейкозов (например, хронический эозинофильный лейкоз), миелопролиферативные заболевания | Эозинофилия может быть паранеопластическим синдромом или прямым следствием опухолевого процесса. |
| Заболевания желудочно-кишечного тракта | Эозинофильный эзофагит, эозинофильный гастроэнтерит, воспалительные заболевания кишечника (болезнь Крона, язвенный колит) | Эозинофилы инфильтрируют стенки ЖКТ, вызывая воспаление и дисфункцию. |
| Кожные заболевания | Пузырчатка, герпетиформный дерматит Дюринга, эозинофильный целлюлит | Эозинофилы могут быть обнаружены в биоптатах кожи. |
| Лекарственная эозинофилия | Реакция на антибиотики (пенициллины, цефалоспорины), НПВС, противосудорожные препараты, некоторые диуретики | Развивается как побочный эффект приема определенных лекарств. |
| Эндокринные нарушения | Недостаточность надпочечников (болезнь Аддисона) | Снижение уровня кортизола может приводить к повышению эозинофилов. |
| Идиопатическая эозинофилия | Синдром гиперэозинофилии | Диагноз ставится при исключении всех других возможных причин эозинофилии. Может быть первичной (клональной) или вторичной. |
| Инфекционные заболевания (непаразитарные) | Некоторые вирусные инфекции (например, ВИЧ), грибковые инфекции | Реже, чем паразитарные, но могут вызывать эозинофилию. |
Показания к сдаче крови
Обнаружение повышенного уровня эозинофилов имеет важное значение для дифференциальной диагностики следующих заболеваний:
- бронхиальная астма;
- паразитарные инфекции;
- ревматоидный артрит;
- состояния с иммунодефицитом;
- онкологические заболевания крови: лимфома, лейкоз;
- аллергические реакции.
Наиболее распространённым способом определения уровня эозинофилов является общий анализ крови. Он назначается всем пациентам, проходящим амбулаторное или стационарное лечение при диагностике различных заболеваний. В некоторых случаях может потребоваться иммуноферментный анализ крови на наличие паразитов, который позволит получить более детальную информацию о паразитарных инфекциях в организме.
| Общий анализ крови (нормальные значения) | ||
| Показатель | Взрослые женщины | Взрослые мужчины |
| Гемоглобин | 120–140 г/л | 130–160 г/л |
| Эритроциты | 3,7—4,7×10^12 | 4—5,1×10^12 |
| Цветовой показатель | 0,85–1,15 | 0,85–1,15 |
| Регакулоциты | 0,2–1,2% | 0,2–1,2% |
| Тромбоциты | 180—320×10^9 | 180—320×10^9 |
| СОЭ | 2–15 мм/ч | 1–10 мм/ч |
| Лейкоциты | 4—9×10^9 | 4—9×10^9 |
| Палочкоядерные | 1–6% | 1–6% |
| Сегментоядерные | 47–72% | 47–72% |
| Эозинофилы | 0–5% | 0–5% |
| Базофилы | 0–1% | 0–1% |
| Лимфоциты | 18-40% | 18-40% |
| Моноциты | 2–9% | 2–9% |
Таблица норм общего анализа крови
Если наблюдается повышение уровня палочкоядерных или сегментоядерных нейтрофилов, рекомендуется пройти полное обследование, так как это может указывать на наличие серьезных заболеваний. Причины этого могут быть разнообразными, но квалифицированный специалист сможет разобраться в ситуации.
Важно! Анализ крови следует сдавать утром натощак. За два дня до теста рекомендуется избегать сладостей, цитрусовых и алкогольных напитков.
Эозинофильный катионный протеин (ECP, или ЭКБ) — это компонент гранул эозинофилов. Белки, содержащиеся в эозинофильных гранулах, уничтожают паразитов, но при этом могут повреждать ткани, ослабленные аллергическими реакциями, такими как бронхиальная астма и другие воспалительные заболевания.
Повышенные уровни эозинофилов связаны с развитием бронхиальной астмы, атипических дерматитов и аллергическими поражениями глаз. Аналогичные симптомы могут наблюдаться при заболеваниях среднего уха, аутоиммунных расстройствах, синдроме хронической усталости, а также при инфекциях и инвазиях различной природы.
ECP обладает высокой токсичностью не только для паразитов, но и для нервных клеток, эпителия и миокарда. Измерение уровня ЭКБ является объективным тестом, который подтверждает участие эозинофилов в проявлении клинических симптомов повышенной чувствительности. Этот тест помогает в диагностике заболеваний и мониторинге эффективности лечения.
ЭКБ также имеет нейротоксические свойства, что усиливает зуд при дерматитах. Установлена положительная связь между увеличением уровня ЭКБ и интенсивностью кожных аллергий. В процессе выздоровления уровень ЕКБ нормализуется.
Часто результаты анализов показывают повышенное количество лимфоцитов у взрослых, и о возможных причинах этого отклонения можно узнать более подробно в статье на нашем сайте.
Анализ крови следует сдавать утром и натощак.
https://youtube.com/watch?v=dSpxBVPLFes
Методы лечения
Эозинофилы, выполняя защитные функции организма, могут стать опасными, если их количество превышает определенные пределы. В местах, где они скапливаются, возникают воспалительные процессы и могут развиваться серьезные заболевания. В связи с этим возникает вопрос: как снизить уровень эозинофилов до безопасного значения?
Лечение эозинофилии должно проводиться врачом-гематологом. Прежде чем начать терапию, специалист выясняет причины повышения уровня эозинофилов. Для этого назначаются дополнительные диагностические процедуры, включая анализы кала и мочи. В зависимости от ситуации могут проводиться тесты на работу почек и печени, а также обследования на наличие инвазий, аллергенов и соединительнотканевых заболеваний. Особое внимание уделяется обследованию беременных женщин.
Если удается точно установить диагноз и устранить причину заболевания, уровень эозинофилов нормализуется одновременно с исчезновением симптомов.
Эозинофилы представляют собой одну из групп лейкоцитов (белых кровяных клеток). Они относятся к нейтрофильному ряду, но имеют свои отличия. Эти клетки немного крупнее, а их ядра содержат меньшее количество долей (обычно 2-3).
При микроскопическом исследовании в цитоплазме эозинофилов можно увидеть обильную зернистость оранжево-розового оттенка, состоящую из множества однородных гранул. При анализе крови эозинофилы подсчитываются в мазке под микроскопом или определяются с помощью гематологического анализатора.
Повышенное содержание эозинофилов в крови у взрослого человека указывает на наличие различных проблем в организме. Высокий уровень может свидетельствовать о аллергической реакции, не всегда острого характера, о различных бактериальных инфекциях или о наличии паразитов-глистов.
Это связано с тем, что эозинофилы — клетки, которые быстро реагируют на указанные проблемы, и вместе с базофилами они являются прямыми маркерами гиперчувствительности в организме.
Роль эозинофилов в организме
Эозинофилы выполняют множество функций, некоторые из которых схожи с задачами других видов белых кровяных клеток. Эти клетки активно участвуют в различных воспалительных процессах, особенно в тех, что связаны с аллергическими реакциями. Кроме того, эозинофилы играют важную роль в физиологических процессах, таких как развитие органов, например, молочной железы после родов.
К основным функциям этих клеток можно отнести:
- локализацию в зонах воспаления;
- защиту от негативного воздействия потенциально опасных веществ;
- уничтожение клеток;
- активность против паразитов и бактерий.
Эозинофилы в крови могут оказывать как положительное, так и отрицательное воздействие. Они препятствуют проникновению опасных микроорганизмов в организм человека, однако в некоторых случаях их активность может приводить к патологическим изменениям. Ярким примером является болезнь Леффлера.
Норма
У взрослых уровень эозинофилов в крови составляет 0,4х10^9/л, тогда как у детей этот показатель может достигать 0,7х10^9/л. Тем не менее, в сравнении с другими иммунными клетками, нормальное содержание эозинофилов как у взрослых, так и у детей варьируется от 1% до 5%.
Увеличение числа эозинофилов в крови и других биологических жидкостях может быть вызвано различными причинами.
Причины повышения эозинофилов в крови
Почему у взрослого человека наблюдается повышение уровня эозинофилов и что это может означать? Увеличение количества эозинофилов в крови приводит к состоянию, известному как эозинофилия. Это явление может проявляться в различных степенях:
- Легкая форма – уровень клеток составляет до 10%
- Средняя форма – от 10 до 15% эозинофилов
- Тяжелая форма – более 15%. В этом случае возможно развитие кислородного голодания на клеточном или тканевом уровне.
В медицине существует удобная аббревиатура, которая помогает запомнить основные причины, способствующие развитию эозинофилии.
ПОКАА – паразитарные инфекции (лямблиоз, аскаридоз, описторхоз), опухолевые процессы, коллагенозы, аллергические реакции, астма. Это пять наиболее распространенных факторов, приводящих к увеличению уровня эозинофилов в крови.
В редких случаях повышение эозинофилов может быть связано с другими заболеваниями:
- Острый лейкоз.
- Туберкулез.
- Наследственная эозинофилия.
- Ревматическая лихорадка (ревматизм).
- Экссудативные реакции различного происхождения.
- Ваготония (раздражение блуждающего нерва), вегето-сосудистая дистония.
- Снижение функциональной активности щитовидной железы (гипотиреоз).
Важно понимать, что эозинофилы не всегда приносят организму пользу. В процессе борьбы с инфекциями они могут сами вызывать аллергические реакции. Когда уровень эозинофилов превышает 5% от общего числа лейкоцитов, это приводит не только к эозинофилии, но и к воспалительным изменениям в тканях в местах их скопления. По такому принципу у детей часто возникают ринит и отек гортани.
Физиологические причины
При первом выявлении повышенного уровня эозинофилов в крови необходимо провести повторное обследование и отслеживать изменения их количества в динамике, анализируя результаты нескольких последовательных тестов.
Повышенные эозинофилы у ребенка
В зависимости от возраста ребенка, факторы, способствующие увеличению уровня клеток, могут быть следующими:
- У новорожденных детей повышенное содержание эозинофилов может быть связано с резус-конфликтом, инфекцией стафилококком, гемолитической болезнью, дерматитами и аллергическими реакциями на медикаменты или пищу.
- У детей в возрасте от полутора до трех лет высокие уровни эозинофилов могут возникать из-за атопического дерматита, аллергии на лекарства и отека Квинке.
- У детей старше трех лет уровень эозинофилов может увеличиваться при наличии бронхиальной астмы или аллергического ринита, во время обострений кожных аллергий, ветрянки, скарлатины, а также при гельминтозах. Кроме того, повышение эозинофилов может быть связано с злокачественными опухолями.
Увеличение эозинофилов в крови не является отдельным заболеванием; все усилия должны быть сосредоточены на выявлении основной причины их повышения и, по возможности, ее устранении.
Что делать?
Если результаты общего анализа крови показали увеличение уровня эозинофилов, необходимо провести дополнительное исследование — биохимический анализ крови. Это поможет выявить заболевание, которое могло привести к такому изменению. Важно обратить внимание на уровень белковых ферментов, находящихся в печени, и другие показатели. Также рекомендуется сдать анализы мочи и кала, чтобы исключить наличие глистов или их яиц.
Лечением эозинофилии занимается гематолог, однако стоит помнить, что это не самостоятельное заболевание, а лишь симптом какого-либо другого недуга. Важно установить причину повышения уровня эозинофилов, после чего будет разработан эффективный план лечения, включающий необходимые медикаменты и физиотерапевтические процедуры.
Эозинофилы — это одна из разновидностей лейкоцитов (белых кровяных клеток). Их выработка активируется при попадании в организм чуждых белковых структур. Количество этих клеток определяется в ходе стандартного общего анализа крови, при этом важно учитывать не только абсолютное значение (количество клеток в единице объема крови), но и их соотношение к общему числу лейкоцитов (выражается в процентах). Когда иммунная система активно борется с болезнью, уровень эозинофилов в крови может повышаться. Однако не всегда изменение их уровня указывает на наличие патологического процесса. Об этом и поговорим подробнее.
Степени эозинофилии у взрослого и у детей
Состояние, при котором уровень эозинофилов в крови повышается, называется эозинофилией.
В нормальных условиях у взрослого человека (независимо от пола) количество этих клеток составляет от 100–120 до 300–350 в одном миллилитре крови. В процентном соотношении к общему числу лейкоцитов это составляет 1–5%. У детей в зависимости от возраста это соотношение может колебаться от 1 до 6–7%.
Существенным считается отклонение уровня эозинофилов от нормы на 10% и более, что указывает на лёгкую степень эозинофилии. Если уровень достигает 15%, это свидетельствует о средней степени; превышение 15% указывает на наличие серьёзной патологии.
Важно также учитывать физиологические изменения в количестве клеток и другие факторы, которые могут влиять на этот показатель.
Непатологические повышения показателя
Первоначально выявленные повышенные уровни эозинофилов в крови требуют повторного анализа и наблюдения за изменением их количества в динамике (через несколько последовательно выполненных исследований).
Причины патологии
При повышении уровня эозинофилов важно определить причину, так как это состояние является признаком какого-либо заболевания, а не самостоятельной болезнью. Увеличение количества этих клеток в крови свидетельствует о активной работе иммунной системы и не всегда требует медицинского вмешательства.
Существует несколько факторов, способствующих развитию эозинофилии:
- Паразитарные инфекции;
- Аллергические реакции;
- Заболевания органов внутренней секреции;
- Гематологические заболевания;
- Кожные патологии;
- Аутоиммунные расстройства;
- Инфекционные болезни;
- Злокачественные новообразования.
Паразиты
Анализ крови может показать наличие эозинофилии, что часто свидетельствует о заражении человека гельминтами. К числу заболеваний, способствующих этому состоянию, относятся:
- Токсокароз;
- Описторхоз;
- Лямблиоз;
- Аскаридоз;
- Филяриоз;
- Стронгилоидоз;
- Малярия;
- Парагонимоз;
- Эхинококкоз;
- Трихинеллёз;
- Амебиаз.
Аллергия
Аллергическая реакция является одной из основных причин увеличения уровня эозинофилов в организме. Это состояние может возникать при следующих заболеваниях:
- Поллиноз;
- Отек Квинке;
- Бронхиальная астма;
- Аллергия на лекарства;
- Сенная лихорадка;
- Сывороточная болезнь;
- Аллергический ринит;
- Крапивница;
- Фасциит;
- Миозит и другие.
Заболевания внутренних органов
Эозинофилия может проявляться при различных заболеваниях следующих органов:
| Лёгкие | Желудочно-кишечный тракт | Сердечно-сосудистая система | Печень |
|---|---|---|---|
| альвеолит | гастрит | инфаркт миокарда | цирроз |
| плеврит | колит | врождённые аномалии | |
| болезнь Леффлера | язвенная болезнь | ||
| саркоидоз | гастроэнтерит | ||
| гистиоцитоз | |||
| аспергиллез | |||
| пневмония | |||
| наличие инфильтратов |
Заболевания крови
Увеличение уровня эозинофилов может быть связано с такими заболеваниями, как эритремия, миелолейкоз, лимфогранулематоз, полицитемия, пернициозная анемия и синдром Сезари.
Дерматологические патологии
Почти каждое кожное заболевание сопровождается увеличением уровня эозинофилов:
- Лишай;
- Вульгарная пузырчатка;
- Контактный или атопический дерматит;
- Пемфигус;
- Экзема;
- Грибковая инфекция.
Аутоиммунные состояния
Анализ крови часто показывает повышенное содержание эозинофилов при склеродермии и системной красной волчанке (СКВ). Кроме того, значительное количество этих клеток может образовываться в процессе отторжения трансплантата.
Инфекции
Инфицирование организма всегда приводит к повышению уровня эозинофилов. Это состояние может быть вызвано как острым процессом, так и обострением хронических заболеваний:
- Скарлатина;
- Туберкулёз;
- Гонорея;
- Мононуклеоз;
- Сифилис и другие.
Злокачественные опухоли
Разные виды злокачественных опухолей, включая лимфомы и лимфогранулематозы, приводят к повышению уровня эозинофилов в крови. Опухолевые образования могут развиваться в различных органах, таких как половые и внутренние органы, щитовидная железа, кожа, желудок и другие. Состояние пациента может значительно ухудшаться при возникновении метастазов.
Особенности эозинофилии у детей
В детском возрасте увеличение уровня эозинофилов чаще всего указывает на наличие аллергической реакции или паразитарной инфекции. Тем не менее, не следует исключать и другие возможные причины, включая внутриутробное заражение плода. В любом случае необходимо пройти полное обследование, чтобы определить, что именно стало причиной изменений в анализе крови.
Диагностика заболевания
Чтобы получить полное представление о состоянии здоровья человека, в первую очередь следует пройти биохимический анализ крови. Это исследование может помочь выявить причины повышения уровня эозинофилов. На основании полученных результатов рекомендуется провести дополнительные обследования:
- Ультразвуковое исследование органов брюшной полости;
- Анализ кала на наличие паразитов и их яиц;
- Анализ мочи;
- Тесты для оценки функции внутренних органов (почки, печень и другие);
- Флюорография легких;
- Аллергологические исследования (анализ слизи, провокационные пробы, спирометрия, пункция суставной жидкости и другие процедуры).
https://youtube.com/watch?v=DuV-xFu4JQM
Лечение эозинофилии
После установления истинной причины изменения формулы крови лечение назначает врач-специалист. В случае патологий крови это будет гематолог; если причиной состояния стали паразиты, то к вам обратится инфекционист; аллергические реакции лечит аллерголог; заболевания легких – пульмонолог и так далее. Не существует универсального метода лечения эозинофилии, поскольку врач принимает во внимание возраст пациента, наличие сопутствующих заболеваний, общее состояние здоровья, принимаемые медикаменты и множество других факторов, рассматривая каждый случай индивидуально.
Не стоит расстраиваться, если уровень эозинофилов повышен в умеренной степени, это может указывать на начало выздоровления и формирование адекватной реакции иммунной системы на инфекцию. Доверьтесь врачу и строго следуйте его рекомендациям.
Влияние образа жизни на уровень эозинофилов
Образ жизни играет значительную роль в формировании уровня эозинофилов в крови. Эозинофилы — это тип белых кровяных клеток, которые участвуют в иммунном ответе и помогают организму бороться с инфекциями, аллергическими реакциями и воспалительными процессами. Изменения в образе жизни могут как способствовать повышению, так и снижению их уровня.
Одним из ключевых факторов, влияющих на уровень эозинофилов, является питание. Диета, богатая аллергенами, такими как молочные продукты, яйца, орехи и морепродукты, может привести к повышению уровня этих клеток. У мужчин, которые часто употребляют продукты с высоким содержанием консервантов и искусственных добавок, также может наблюдаться увеличение эозинофилов. Важно отметить, что индивидуальная чувствительность к определенным продуктам может варьироваться, и у некоторых людей даже небольшое количество аллергена может вызвать значительное увеличение эозинофилов.
Физическая активность также оказывает влияние на уровень эозинофилов. Регулярные занятия спортом способствуют улучшению общего состояния здоровья и могут помочь в нормализации уровня этих клеток. Однако чрезмерные физические нагрузки, особенно в сочетании с недостаточным восстановлением, могут привести к стрессу и воспалению, что, в свою очередь, может способствовать увеличению эозинофилов.
Стресс является еще одним важным фактором. Хронический стресс может вызывать различные изменения в организме, включая активацию иммунной системы и увеличение выработки эозинофилов. У мужчин, которые испытывают постоянные стрессовые ситуации, уровень этих клеток может быть значительно выше, чем у тех, кто ведет более спокойный образ жизни.
Курение и употребление алкоголя также могут оказывать влияние на уровень эозинофилов. Никотин и алкоголь могут вызывать воспалительные процессы в организме, что может привести к увеличению количества эозинофилов. Кроме того, курение связано с повышенным риском развития аллергических заболеваний, что также может способствовать увеличению уровня этих клеток.
Наконец, качество сна и режим отдыха играют важную роль в поддержании нормального уровня эозинофилов. Хроническое недосыпание и нарушение режима сна могут привести к ослаблению иммунной системы и увеличению воспалительных процессов, что, в свою очередь, может способствовать повышению уровня эозинофилов в крови.
Таким образом, образ жизни, включая питание, физическую активность, уровень стресса, привычки и режим сна, может существенно влиять на уровень эозинофилов у мужчин. Осознание этих факторов и их корректировка могут помочь в нормализации уровня эозинофилов и улучшении общего состояния здоровья.
Профилактика повышения эозинофилов
Одним из ключевых аспектов профилактики является соблюдение здорового образа жизни. Это включает в себя регулярные физические нагрузки, которые способствуют улучшению кровообращения и укреплению иммунной системы. Умеренные физические упражнения, такие как ходьба, плавание или занятия спортом, могут помочь поддерживать нормальный уровень эозинофилов.
Правильное питание также играет важную роль. Рацион, богатый витаминами, минералами и антиоксидантами, помогает организму эффективно функционировать и снижает риск развития заболеваний, которые могут привести к повышению эозинофилов. Важно включать в свой рацион свежие фрукты и овощи, цельнозерновые продукты, нежирные белки и полезные жиры. Избегание продуктов, вызывающих аллергические реакции, также может помочь в профилактике.
Контроль за состоянием здоровья и регулярные медицинские обследования являются важными мерами профилактики. Мужчинам рекомендуется проходить плановые осмотры у врача, особенно если у них есть предрасположенность к аллергиям или хроническим заболеваниям. Это позволит своевременно выявлять и лечить заболевания, которые могут привести к повышению уровня эозинофилов.
Избегание контакта с аллергенами — еще один важный аспект профилактики. Если у мужчины есть известные аллергии, необходимо минимизировать контакт с аллергенами, такими как пыльца, шерсть животных или определенные продукты питания. Использование антигистаминов и других препаратов, назначенных врачом, может помочь в контроле аллергических реакций.
Кроме того, важно уделять внимание психоэмоциональному состоянию. Стресс и нервное напряжение могут негативно сказываться на иммунной системе и способствовать повышению уровня эозинофилов. Практики релаксации, такие как медитация, йога или просто прогулки на свежем воздухе, могут помочь снизить уровень стресса и улучшить общее самочувствие.
В заключение, профилактика повышения эозинофилов у мужчин требует комплексного подхода, включающего здоровый образ жизни, правильное питание, регулярные медицинские обследования и управление стрессом. Соблюдение этих рекомендаций поможет поддерживать нормальный уровень эозинофилов и общее здоровье.
Связь эозинофилии с другими заболеваниями
Эозинофилия, или повышенное содержание эозинофилов в крови, может быть связана с различными заболеваниями и состояниями. Эозинофилы — это тип белых кровяных клеток, которые играют важную роль в иммунной системе, особенно в борьбе с паразитарными инфекциями и аллергическими реакциями. Повышение их уровня может указывать на наличие определенных патологий.
Одной из наиболее распространенных причин эозинофилии является аллергическая реакция. Это может быть вызвано различными аллергенами, такими как пыльца, шерсть животных, пищевые продукты или медикаменты. При контакте с аллергеном организм начинает вырабатывать антитела, что приводит к увеличению числа эозинофилов, которые помогают в борьбе с аллергической реакцией.
Кроме того, эозинофилия может быть связана с инфекциями, особенно паразитарными. Паразиты, такие как глисты, могут вызывать увеличение уровня эозинофилов, так как организм активирует иммунный ответ для борьбы с ними. Это наблюдается, например, при таких заболеваниях, как аскаридоз или трихинеллез.
Некоторые аутоиммунные заболевания также могут приводить к повышению уровня эозинофилов. Например, системная красная волчанка и синдром Чург-Стросса могут вызывать эозинофилию как часть общего воспалительного процесса. В таких случаях эозинофилы могут участвовать в патогенезе заболевания, усугубляя воспаление и повреждение тканей.
Эозинофилия может также быть признаком некоторых онкологических заболеваний, таких как лимфома или рак легких. В этих случаях повышенное количество эозинофилов может быть связано с реакцией организма на опухолевые клетки или с выделением специфических веществ, которые стимулируют их выработку.
Кроме того, существуют и другие состояния, которые могут приводить к повышению уровня эозинофилов, такие как экзема, бронхиальная астма и некоторые заболевания легких. В этих случаях эозинофилия может быть частью аллергического или воспалительного процесса, который требует комплексного подхода к диагностике и лечению.
Важно отметить, что для точного определения причины эозинофилии необходимо провести комплексное обследование, включая анализы крови, аллергологические тесты и, при необходимости, дополнительные исследования. Это позволит выявить основное заболевание и назначить соответствующее лечение, направленное на нормализацию уровня эозинофилов и улучшение состояния пациента.